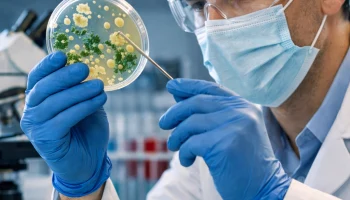
В России раскрыли тайный механизм защиты бактерий

Сайт Краснодара
![]() |
Приветствуем жителей и гостей Краснодара, тех, кому интересен наш город и кто хотел бы узнать о нем еще больше. На страницах этого портала собрано множество полезной и интересной информации, связанной с разными сторонами жизни края. |
Городской сайт — это:
- свежая, актуальная информация, которая поступает к нам «из первых рук»;
- подборка объявлений от частных лиц и компаний;
- раздел фото, где собраны городские фотографии, пейзажи, портреты, выполненные местными жителями;
- удобное место для общения, дискуссий и споров на разные темы, которые волную горожан;
- быстрый доступ к справочной информации, помощь гостям города;
Наш Сайт Краснодара создавался для людей с 2012 года и продолжает совершенствоваться и наполняться полезными сведениями и фактами каждый день ❤️ для Вас! Нам важно, чтобы на наших страницах каждый пользователь нашел для себя что-то интересное, важное, нужное. Для удобства поиска на сайте предусмотрено множество продуманных и тематических разделов.
О чем расскажет сайт города Краснодара?
- Об истории и современности города и края. Раздел «О городе» будет интересен не только туристам, которые впервые собираются посетить наши места, но и горожанам.
- Об актуальных новостях политики, спорта, культуры, о происшествиях, которые произошли в Краснодаре и Краснодарском крае;
- О погоде. Прогноз на сегодняшний день и последующие 5 дней по городу, региону, стране в целом.
- О фирмах, компаниях, которые предлагают свои товары и услуги горожанам. В разделе «Фирмы» содержится понятный каталог, который ежедневно пополняется новой компанией. Любой желающий может зарегистрироваться на сайте Краснодара и добавить объект в этот раздел.
- Об актуальных вакансиях, реализуемых объектах, об услугах и многом другом. Для всего этого городской сайт Краснодара предусматривает раздел «Объявления». Его может бесплатно использовать любой пользователь. Разместить объявление на страницах нашего ресурса очень легко, так же как и откликнуться на имеющееся.
Кроме указанных разделов, сайт содержит большой тематический блок «Общение», в рамках которого предусмотрен форум, создание блогов, клубов, гороскоп. Раздел «Общение» наверняка привлечет неравнодушных горожан, гостей Краснодара. На форуме они смогут обсудить новости, поделиться впечатлениями, поговорить о «женском» и «мужском», найти единомышленников.
Сегодня, наш официальный сайт г Краснодара дает бесплатную возможность зарегистрироваться, чтобы принимать участие в общении, а еще, чтобы публиковать объявления, добавлять в каталог коммерческие объекты. Процедура регистрации проста и понятна. При желании любой пользователь может входить на ресурс без регистрации, используя популярные социальные сети.
Краснодар онлайн
Теперь так просто попасть на наш ресурс. Здесь всегда многолюдно, всегда есть актуальная информация и полезные сведения, городские новости и оригинальные фото. Удобная навигационная система позволит вам беспрепятственно совершать путешествие по сайту.
Мы уверены, вам понравится наш Краснодар. Вы обязательно найдете на страницах ресурса то, что нужно в режиме онлайн!
Юридический момент использования Краснодарского сайта
При использовании нашего сайта мы просим Вас ознакомиться с 3-мя важными документами:
1. Политика обработки персональных данных.
2. Использование файлов Сookie и сервиса Яндекс.Метрики.
3. Правила сайта.
Если вы не хотите ознокамливаться или с чем-то несогласны - просим Вас незамедлительно покинуть наш сайт. Но если Вас все устраивает и Вы со всем согласны - то скорее пройдите регистрацию для того что бы не пропустить ничего важного и получить еще больше возможностей не только в Кубанской столице и на просторах Юга ☀️!